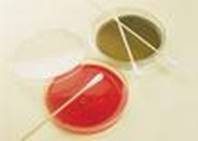

“To Test or Not to Test” for
Birth Defects-
A Modern Geneticist’s Dilemma
Ms. McLean
A. Phillip Randolph HS

Introduction:
Recent advances in
genetics technology include the Human Genome Research Project – allows
the sequencing of DNA and the analysis of genes quickly and efficiently. The implications for this huge project
include the genetic information that isolate and analyze diseased-linked genes,
generate improved methods to diagnose inherited and acquired genetic diseases,
and investigate treatment strategies. Such diseases being isolated include
diabetes, schizophrenia, and breast cancer, among others.
However, there is a
lack of understanding of these issues as it relates to ensuring that genetic
information is used for the benefit of individuals and society. That is, the privacy and fair use of genetic
information; responsible clinical integration of new genetic technologies
ethical issues surrounding the conduct of genetic research; and professional
and public education about these issues.
As the knowledge
grows about the genetic basis of disease, so does the potential for presenting
parents-to-be with a very serious dilemma. Tests can show, to a very great
extent, the likelihood that their baby may be born with a serious birth defect.
The question then becomes what to do about this, if anything. The issue presents a problem for society as
a whole is also a great one. The costs involved in extensive medical care for a
child born with serious defects are usually borne by society in some manner. On
the other hand, ending a pregnancy by abortion involved its own set of social
issues.
You have been asked
to join a community activist group to research the extent of the problem today
and to lobby congress for laws to better deal with this issue. Your work will
have great importance to thousands of Americans today and maybe millions in the
future- good luck!


The Task:
 Working
in groups of five, you will research the issues that involve genetic testing
and birth defect detection using the resources listed below, and the PPA
worksheets. Each group will develop a presentation of about five minutes
discussing the advantages and disadvantages of genetic testing.
Working
in groups of five, you will research the issues that involve genetic testing
and birth defect detection using the resources listed below, and the PPA
worksheets. Each group will develop a presentation of about five minutes
discussing the advantages and disadvantages of genetic testing.
Process:
Ø
·You will be divided into groups of five
to undertake the task, make a report using PowerPoint presentation of ten
slides.
Ø
·Each group is required to organize
themselves into assigned roles to complete the tasks:
§
Your teacher will select members of each group to fill each of
the following roles:
§
Group Leader- Who will organize the
group and coordinate the group’s effort. The leader also assists all other
members in completing their tasks
§
Recorder and Secretary- Writes the results of
researchers in a format that can be presented. The Recorder keeps all research
materials for the
group’s use
§
Researchers- These two will look
at the websites and present the data for the groups as a whole to analyze
§
Presenter- Who will describe the
group’s findings to the class as a whole. The Presenter may also work with the
whole group in developing a format for the presentation, which may be a poster
board
PowerPoint, etc.
Ø
·Students will be required to follow the
process of the Public Policy Analyst (PPA) by reviewing the following steps to
guide them in the process with their group:
1.
Identifying the Problem, and Worksheet #1
2.
Gathering Evidence, and Worksheet # 2
3.
Identify Causes of the problem, and Worksheet # 3
4.
Evaluate the Policy, and Worksheet #4
5.
Develop a solution to the Problem, and Worksheet #5
6.
Selecting the Best Solution, and Worksheet #6

Resources:
Birth Defects & Genetics: The Genetics Revolution
Genetic Screening for Birth Defects
Testing for Birth Defects
Ethical Issues With
Genetic Testing in Pediatrics --
Committee on Pediatrics
Ethical Issues in Genetic
Screening and Testing, Gene Therapy, and Scientific Conduct
Ethics and genetic testing | Science Buzz
Genetic testing – A
World Health Organization Report
USCCB - (SHV) - The Promise and
Peril of Genetic Screening- A Comment by the Catholic Church
A University of Pennsylvania
report of possible risks and ethical issues
Rubric:
|
||||||||||||||||||||||||||||||||||||||||||
|
Conclusion:
Upon
completing this project you and your teammates will have examined a national
social problem and how it affects people right here in the
Standards:
Science Standards
S5e:
Identifies problems; proposes and implement solutions; and evaluates the
accuracy, design, and outcomes of investigations.
S5f:
Works individually and in teams to collect and share information and
ideas.
S7e:
Communicates in a form suited to the purpose and the audience.
Communication Arts Standards
E1c: Read and
comprehend informational materials.
E2a: Produce a
report of information.
E3c: Prepare and
deliver a group presentation.